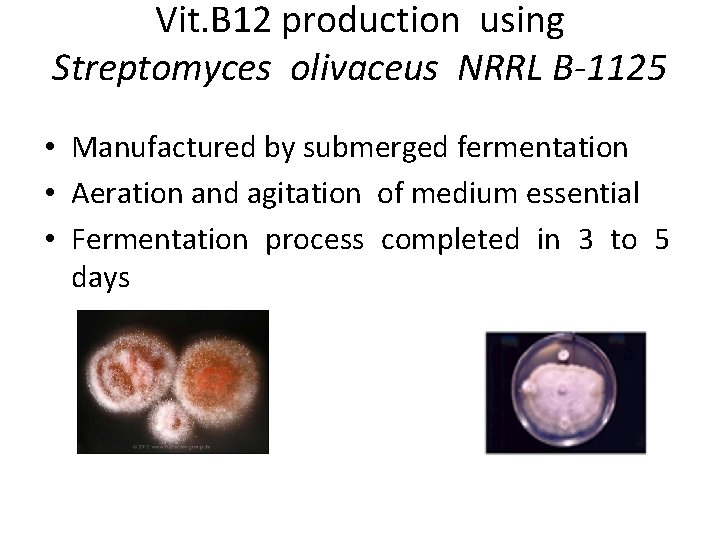
Vit. B 12 production using Streptomyces olivaceus NRRL B-1125 • Manufactured by submerged fermentation

Microbial Kinetics and Substrate utilization in Fermentation Batch

Microbial Kinetics and Substrate utilization in Fermentation

Batch culture and Kinetics of Microbial growth in batch culture • After inoculation the growth rate of the cells gradually increases. • The cells grow at a constant, maximum, rate and this period is known as the log or exponential, phase.

Growth of a typical microbial culture in batch conditions

The rate of growth is directly proportional to cell concentration or biomass i. e. dx/dt α X dx/dt = μX -----1 Where, X is the concentration of microbial biomass, t is time, in hours μ is the specific growth rate, in hours -1

• On integration of equation (1) from t=0 to t=t , we have: xt = xo e μt ----- 2 Where, • Xo is the original biomass concentration, • Xt is the biomass concentration after the time interval, t hours, • e is the base of the natural logarithm.

• On taking natural logarithms of equation (2) we have : In Xt = In Xo + μt (3)

• Therefore, a plot of the natural logarithm of biomass concentration against time should yield a straight line, the slope of which would equal to μ. • During the exponential phase nutrients are in excess and the organism is growing at its maximum specific growth rate, ‘μmax ‘ for the prevailing conditions.

• Typical values of μmax for a range of microorganisms are given below in the Table.

Effect of substrate concentration on microbial growth Whether the organism is unicellular or mycelia the growth is influenced by consumption of nutrients and the excretion of products. The cessation of growth may be due to the depletion of essential nutrient in the medium (substrate limitatioln), the accumulation of some autotoxic product of the organism in the medium (toxin limitation) or a combination of the substrate limitation and toxin limitation. The nature of the limitation of growth may be discussed by growing the organism in the presence of a range of substrate concentrations and plotting the biomass concentration at stationary phase against the initial substrate concentration is shown given below in fig 2: FIG. 2. The effect of initial substrate concentration on the biomass concentration at the onset of stationary phase, in batch culture.

From figure 2 it may be seen that over the zone A to B due to an increase in initial substrate concentration gives a proportional increase in the biomass occur at stationary phase. This relation between increase in initial substrate concentration and proportional increase in the biomass may be described by equation: X = Y(SR - s) -----(3) Where, X -is the concentration of biomass produced, Y -is the yield factor (g biomass produced g-1 substrate consumed), SR -is the initial substrate concentration, and s -is the residual substrate concentration. • Thus, equation (3) may be used to predict the production of biomass from a certain amount of substrate

• In Fig. 2: • Over the zone A to B: s = 0; at the point of cessation of growth. • Over the zone C to D an increase in the initial substrate concentration does give a proportional increase in biomass due to the exhaustion of another substrate or the accumulation of toxic products

Monod Equation The decrease in growth rate and the cessation of growth due to the depletion of substrate, may be described by the relationship between μ and the residual growth limiting substrate. This relationship is represented by a equation given by Monod in 1942 is know as Monod equation. Based upon Michaelish-Menten kinetics. According to Monad equation μ = μmax. S /Ks + S (4) • Where, • S is residual substrate concentration, • Ks is substrate utilization constant, numerically equal to substrate concentration when μ is half of μmax. • Ks s a measure of the affinity of the organism with substrate It tell about the relationship between specific growth rate ‘μ’ and growth limiting substrate concentration ‘S’.

Fig: 3 The effect of residual limiting substrate concentration on specific growth rate of a hypothetical bacterium. In the above figure The zone A to B is equivalent to the exponential phase in batch culture where substrate concentration is in excess and growth is at μmax. The zone C to A is equivalent to the deceleration phase of batch culture where the growth of the organism is due to the depletion of substrate to a growth-limiting concentration which will not support μmax.

Some representative values of Ks for a range of micro-organisms and substrates Typical values of K, for a range of organisms and substrates are usually very small and therefore the affinity for substrate is high.

• If the organism has a very high affinity for the limiting substrate (a low Ks value) the growth rate will not be affected until the substrate concentration has declined to a very low level. Thus, the deceleration phase for such a culture would be short. • However, if the organism has a low affinity for the substrate (a high Ks value) the growth rate will be deleteriously affected at a relatively high substrate concentration. Thus, the deceleration phase for such a culture would be relatively long. • The biomass concentration at the end of the exponential phase is at its highest level. Therefore the decline in substrate concentration will be very rapid so that the time period during which the substrate concentration is close to Ks is very short. • The stationary phase in batch culture is that point where the growth rate has declined to zero. This phase is also known as the maximum population phase.

Optical Density Log CFU/ml Growth Curve Lag

Lag phase Three causes for lag: physiological lag low initial numbers appropriate gene(s) absent growth approx. = 0 (d. X/dt = 0)

Exponential phase Nutrients and conditions are not limiting growth = 2 n or X = 2 n. X 0 Where X 0 = initial number of cells X = final number of cells n = number of generations 20 20 21 21 22 22 23 23 24 24 n 2 2 n

Example: An experiment was performed in a lab flask growing cells on 0. 1% salicylate and starting with 2. 2 x 104 cells. As the experiment below shows, at the end there were 3. 8 x 109 cells. This is an increase is 5 orders of magnitude!! How many doublings or generations occurred? X = 2 n. X 0 3. 8 x 109 = 2 n(2. 2 x 104) 1. 73 x 105 = 2 n log(1. 73 x 105) = nlog 2 17. 4 = n Cells grown on salicylate, 0. 1%

Calculating growth rate during exponential growth d. X/dt = u. X where u = specific growth rate (h-1) Rearrange: d. X/X = udt Integrate: ln. X = ut + C, where C = ln. X 0 d. X/dt = u. X where u = specific growth rate (h-1) X = X 0 eut ln. X = ut + ln X 0 or y = mx + b (equation for a straight line) Note that u, the growth rate, is the slope of this straight line

Calculating growth rate during exponential growth d. X/dt = u. X where u = specific growth rate (h-1) Rearrange: d. X/X = udt Integrate: ln. X = ut + C, where C = ln. X 0 ln. X = ut + ln X 0 or X = X 0 eut y = mx + b (equation for a straight line) Note that u, the growth rate, is the slope of this straight line

Find the slope of this growth curve ln. X = ut + ln X 0 or u = ln. X – ln. X 0 t – t 0 u = ln 5. 5 x 108 – ln 1. 7 x 105 = 2 hr-1 8. 2 - 4. 2

Now calculate the doubling time If you know the growth rate, u, you can calculate the doubling time for the culture. ln. X = ut + ln X 0 For X to be doubled: X/X 0 = 2 or: 2 = eut From the previous problem, u = 2 hr-1, 2 = e 2(t) t = 0. 34 hr = 20. 4 min What is fastest known doubling time? Slowest?

How can you change the growth rate? ? ? When under ideal, nonlimiting conditions, the growth rate can only be changed by changing the temperature (growth increases with increasing temp. ). Otherwise to change the growth rate, you must obtain a different microbe or use a different substrate. In the environment (non-ideal conditions), the growth rate can be changed by figuring out what the limiting condition in that environment is. Question: Is exponential growth a frequent occurrence in the environment?

Growth Curve Stationary

Stationary phase nutrients become limiting and/or toxic waste products accumulate growth = death (d. X/dt = 0) Death phase death > growth (d. X/dt = -kd. X)

Monod Equation The exponential growth equation describes only a part of the growth curve as shown in the graph below. The Monod equation describes the dependence of the growth rate on the substrate concentration: . u = um S Ks + S u = specific growth rate (h-1) um = maximal growth rate (h-1) S = substrate concentration (mg L-1) Ks = half saturation constant (mg L-1)

Combining the Monod equation and the exponential growth equation allows expression of an equation that describes the increase in cell mass through the lag, exponential, and stationary phases of growth: u = um. S Ks + S Monod equation d. X/dt = u. X u = d. X/Xdt Exponential growth equation d. X/dt = um. S. X Ks + S Does not describe death phase!

There are two special cases for the Monod growth equation 1. At high substrate concentration when S>>Ks, the Monod equation simplifies to: d. X/dt = um. X growth will occur at the maximal growth rate. 2. Ks At low substrate concentration when S<< Ks, the Monod equation simplifies to: d. X/dt = um. S. X Ks growth will have a first order dependence on substrate concentration (growth rate is very sensitive to S). Which of the above two cases is the norm for environmental samples?

Growth in terms of substrate loss In this case the growth equation must be expressed in terms of substrate concentration. The equations for cell increase and substrate loss can be related by the cell yield: d. S/dt = -1/Y (d. X/dt) where Y = cell yield Y = g cell mass produced g substrate consumed Glucose (C 6 H 12 O 6) 0. 4 Pentachlorophenol (C 6 Cl 5 OH) 0. 05 Octadecane (C 18 H 38) 1. 49

Growth in terms of substrate loss d. S/dt = -1/Y (d. X/dt) Combine with: d. X/dt = um. S. X Ks + S d. S/dt = - um (S. X) Y (Ks + S) Which parts of this curve does the equation describe?

Fermentation technology for production of various industrial compunds(vitamins, antibiotics, organic acid, etc)

Microbial products by fermentation Technology • Primary metabolites Small molecules of living cells Intermediates or end products of the pathway. Related to synthesis of microbial cells in the growth phase. Include alcohols, amino acids, nucleotides, organic acids, polyols, vitamins, and enzymes e. g. Lactic acid, citric acid • Secondory metabolites. Accumulate following active growth. Have no direct relationship to synthesis of cell material and natural growth Include antibiotics and toxins

Primary metabolites- Secondory metabolites-

Primary metabolites They are compounds made during the ordinary metabolism of the organism during the growth phase. A common example is ethanol or lactic acid, produced during glycolysis. Citric acid is produced by some strains of Aspergillus niger as part of the citric acid cycle to acidify their environment and prevent competitors from taking over. Glutamate is produced by some Micrococcus species, and some Corynebacterium species produce lysine, threonine, tryptophan and other amino acids. All of these compounds are produced during the normal "business" of the cell and released into the environment. There is therefore no need to rupture the cells for product recovery.

Secondory metabolites. They are compounds made in the stationary phase; penicillin, for instance, prevents the growth of bacteria which could compete with Penicillium molds for resources. Some bacteria, such as Lactobacillus species, are able to produce bacteriocins which prevent the growth of bacterial competitors as well. These compounds are of obvious value to humans wishing to prevent the growth of bacteria, either as antibiotics or as antiseptics (such as gramicidin S. Fungicides, such as griseofulvin are also produced as secondary metabolites. [Typically secondary metabolites are not produced in the presence of glucose or other carbon sources which would encourage growth, [8]and like primary metabolites are released into the surrounding medium without rupture of the cell membrane.

Vitamin production by Fermentation Technology • Vitamins are defined as essential micronutrients that are required in trace quantity and are very important compounds in diet • Synthesized by prototrophic microorganisms • Microbes excrete vitamins in excess of their metabolic needs under highly specific and artificial condition

• Vitamin B 12 • Vitamin B 2 • Vitamin C • pro. Vitamin A

Micro –organisms in industrial production of vit. B 12 Streptomyces griseus , S. olivaceus , Bacillus megaterium , B. coagulans , Pseudomonas denitrificans , Propionibacterium freudenreichii , P. shermanii and a mixed fermentation of a Proteus spp and a Pseudomonas sp
Vit. B 12 production using Streptomyces olivaceus NRRL B-1125 • Manufactured by submerged fermentation • Aeration and agitation of medium essential • Fermentation process completed in 3 to 5 days

Inoculum prepation • Pure slant culture of Streptomyces olivaceus NRRL B-1125 is inoculated and grown in 100 to 250 ml of inoculum medium. • Seeded flask are kept on shaker for incubation. • Flask cultures are used to inoculate large amount of inoculum media arranged in series of tank. • 2 or 3 successive transfers are made to obtain required amount of inoculum cultures. • Inoculum of production tank must be 5% of the volume of production medium

Industrial production of vitamins 42

Production medium • Consist of carbohydrate , proteinaceous material , and source of cobalt and other salts. Components Distillers solubles Dextrose Ca. CO 3 COCl 2. 6 H 2 O Amount ( %) 4. 0 0. 5 to 1 0. 5 1. 5 to 10 p. p. m. • Sterilization of medium batchwise or continuously. • Batch – medium heated at 250°F for 1 hr • Continuous – 330°F for 13 min by mixing with live steam. 43

Temperature , p. H , aeration and agitation • Temperature : 80°F • p. H : At starting of process p. H falls due to rapid consumption of sugar, then rises after 2 to 4 due to lysis of mycelium p. H 5 is maintained with H 2 SO 4 and reducing agent Na 2 SO 4. • Aeration and agitation : Optimum rate of aeration is 0. 5 vol air/vol medium/min. Excess aeration cause foaming. 44

Antifoam agent , prevention of contamination • Antifoam agent : soya bean oil , corn oil, lard oil and silicones (sterilized before adding) . • Prevention of contamination : essential to maintain sterility , contamination results in reduced yields , equipments must be sterile and all transfers are carried out under aseptic conditions. Industrial production of vitamins 45

Yields • Yield of cobalamin are usually in the range of 1 to 2 mg. per litre in the fermented broth

Recovery • Cobalamin associated with mycelium- boiling mixture at p. H 5 liberates the cobalamin quantitatively from mycelium. • Broth containing cobalamin is subjected to further work up depending on type of product to be produced

Recovery contd…. • Filtration - to remove mycelium. • Filtered broth treated with cyanide – (cobalamin to cyanocobalamin). • Adsorption chromatography , ion exchange chromatography – adsorbents : activated charcoal , bentonite , fuller’s earth. Bentonite Fuller’s earth

• Elution : water, water-acetone and solution of sodium cyanide or sodium thiocyanate. • further extraction – countercurrent distribution b/w cresol, amyl phenol or benzyl alcohol and water or single extraction into organic solvent (phenol)

Recovery contd…. • To aqueous concentrates , dissolve a Zn salt in a slight acidic solution & then rise the p. H to bring about precipitation of Zn. OH(impurities are removed). • Chromatography on alumina & crystallization from -acetone , ethanol-acetone, or acetone-water. Industrial production of vitamins methanol 50

Recovery contd…. • To use as feed supplement , final fermented broth is evaporated to dryness. • Final broth contain 3% solids – in vacuo evaporation (15 to 20 % solid content). • Syrup – drum dried or spray dried. (contain 10 to 30 mg. lb. of cobalamin)

Beta- carotene or provitamin A Provitamin A -----> Vitamin A (intestine) • • • Fat soluble Deficiency leads to night blindness Best source is liver and whole milk also coloured fruits and vegetables • • • Isoprene derivatives Tetraterpenoids with eight isoprene residues 400 naturally occurring carotenoids: b-carotene, a-carotene, d-carotene, lycopene, zeaxanthin Carotenoids Used as food colorants and animal feed supplements for poultry and aquaculture, carotenoids play an increasing role in cosmetic and pharmaceutical applications due to their antioxidant properties. The pigments are often regarded as the driving force of the nutraceutical boom, since they not only exhibit significant anticarcinogenic activities but also promote ocular health, can improve immune response, and prevent chronic degenerative diseases.

Commercial production Submerged Fermentation process Microbial fermentation Blakeslea trispora (high yeild; 7 g/L) Phycomyces blakesleeanus Choanephora cucurbitarum Corn starch, soyabean meal, b-ionone, antioxidants stimulators Trisporic acid: act as microbial sex hormone, improves yield b-Ionone: incr b-carotene syn by incr enzyme activity Purified deodorized kerosene increases solubility of hydrophobic substrates Recovery: b- carotene rich mycelium used as feed additive Mycelium is dehydrated by methanol, extracted in methylene chloride and crystallized which is 70 -85% pure DSM Nutritional Products (Switzerland) and BASF (Germany) dominate the market with their chemical synthesis processes, but Chinese competitors are catching up.

Halophilic green microalgae Dunaliella salina. It accumulates the pigments in oil glo- bules in the chloroplast interthylakoid spaces, protecting them against photoinhibition and photodestruction. Excessive pigment formation in D. salina is achieved by numerous stress factors like high temperature, lack of nitrogen and phosphate but excess of carbon, high light intensity, and high salt concentration, the latter two having the highest impact. Dried D. salina biomass for sale contains 10– 16% carotenoids, mainly b-carotene. In addition crystalline material obtained after extraction with edible oil is also sold.

Primary Metabolites: Organic Acids Organic acids are produced by through metabolisms of carbohydrates. They accumulate in the broth of the fermenter from where they are separated and purified. Glycolysis Krebs cycle I. Terminal end products lactic acid (pyruvate, alcohol) Propionic acid II. Incomplete oxidation of sugars (glucose) Itaconic acid citric acid III. Dehydrogenation of alcohol with O 2 Gluconic acid acetic acid Manufactured on large scale as pure products or as salts

CITRIC ACID: industrial uses Flavoring agent In food and beverages Jams, candies, deserts, frozen fruits, soft drinks, wine Antioxidants preservative and Chemical industry Antifoam Treatment of textiles Metal industry, pure metals +citrate (chelating agent) Acidifyer Flavoring Chelating agent Primary metabolite Present in all organisms Agent for stabilization of Fats, oil or ascorbic acid Stabilizer for cheese preparation Pharmaceutical industry Trisodium citrate (blood preservative) Preservation of ointments and cosmetics Source of iron Detergent cleaning industry Replace polyphosphates

Commercial Production Strains that can tolerate high sugar and low p. H with reduced synthesis of undesirable by products (oxalic acid, isocitric acid, gluconic acid) Glucose Pyruvate Aspergillus niger A. clavatus Pencillium luteum MEDIUM CYTOPLASM Pyruvate CO 2 Pyr carboxylase OXA Malate Pyruvate Pyr Dehydrogenase Acetyl Co. A Malate CO 2 OXA MITOCHONDRIA Succinyl Co. A Fumarate Citrate synthase citric acid a-KG 100 g sucrose --- 112 g any citric acid or 123 g citric acid-1 hydrate

Factors for regulation Ø CARBOHYDRATE SOURCE: sugar should be 12 -25% Ø Molasses (sugar cane or sugar beet) Ø Starch (potato) Ø Date syrup Ø Cotton waste Ø Banana extract Ø Sweet potato pulp Ø Brewery waste Ø Pineapple waste High sugar conc incr uptake and production of citric acid Ø TRACE METALS: Ø Mn 2+, Fe 3+, Zn 2+ incr yield Ø Mn 2+ incr glycolysis Ø Fe 3+ is a cofator for enzymes like aconitase Ø p. H: incr yield when p. H below 2. 5, production of oxalic acid and gluconic acid is suppressed and risk of contamination is minimal Ø DISSOLVED O 2: high O 2, sparging or incr aeration can affect if interrupted Ø NITROGEN SOURCE: addition of ammonium stimulates overproduction, molasses is good source of nitrogen

Citric acid production Surface fermentation submerged fermentation Solid liquid Stirred Airlift Bioreactor bioreactor N alkanes (C 9 -C 23) can also be used to produce citric acid; can result in excess production of isocitric acid

ACETIC ACID: industrial uses

ACETIC ACID Incomplete oxidation of ethanol Vinegar is prepared from alcoholic liquids since ceturies NAD+ NADH +H+ NADP +H+ CH 3 CH 2 OH---- CH 3 CHO---- CH 3 CH(OH)2 ------- CH 3 COOH Ethanol acetaldehyde hydrate Alcohol dehydrogenase Acetaldehyde dehydrogenase Gluconobacter, Acetobacter with acid tolerant A. aceti One molecule of ethanol one molecule of acetic acid is produced 12% acetic acid from 12% alcohol Clostridium thermoaceticum It is an obligate anaerobe, Grampositive, spore-forming, rod-shaped, thermophilic organism with an optimum growth temperature of 55– 60 o C and optimum p. H of 6. 6– 6. 8.

VINEGAR: 4% by volume acetic acid with alcohol, salts, sugars and esters flauoring agent in sauces and ketchups, preservative also Wine, malt, whey (surface or submerged fermentation process) Surface: trickling generator; fermentale material sprayed over surface, trickle thro shavings contaning acetic acid producing bacteria; 30 o. C (upper) and 35 o. C (lower). Produced in 3 days. Submerged: stainless steel, aerated using suction pump, production is 10 X higher Clostridium thermoaceticum (from horse manure) is also able to utilize fivecarbon sugars: 2 C 5 H 10 O 5 --- 5 CH 3 COOH A variety of substrates, including fructose, xylose, lactate, formate, and pyruvate, have been used as carbon sources in an effort to lower substrate costs. This factor is also important if cellulosic renewable resources are to be used as raw materials. Typical acidogenic bacteria are Clostridium aceticum, C. thermoaceticum, Clostridium formicoaceticum, and Acetobacterium woodii. Many can also reduce carbon dioxide and other one-carbon compounds to acetate.

1 mol 2 moles 1 mol CODH These enzymes are metalloproteins; for example, CODH contains nickel, iron, and sulfur; FDH contains iron, selenium, tungsten, and a small quantity of molybdenum; and the corrinoid enzyme (vitamin B 12 compound) contains cobalt. C. thermoaceticum does not have any specific amino acid requirement; nicotinic acid is the sole essential vitamin

LACTIC ACID: industrial uses Technical grade 20 -50% >90% Food additive (sour flour and dough) Ester manufacture Textile industry Glucose G 3 P dehydrogenase Pharmaceutical grade Food grade >80% 1, 3 -biphosphoglycerate Intestinal treatment (metal ion lactates) Lactic acid NAD+ LDH (Lactate NADH +H+dehydrogenase) Pyruvate

LACTIC ACID 2 isomeric forms L(+) and D(-) and as racemic mixture DL-lactic acid First isolated from milk Toady produced microbial Heterofermentation Homofermentation Other than lactate products only lactate as product Lactobacillus Mostly one isomer is produced L. delbrueckii Glucose L. leichmanni L. bulgaricus L. helvetii (lactose) L. lactis ------L. amylophilus ---- Whey Maltose Starch

LACTIC ACID: production process 1 mol of glucose gives 2 moles of lactic acid; L lactic acid is predominantly produced Fermentation broth (12 -15% glucose, N 2, PO 4, salts micronutrients) p. H 5. 5 -6. 5/temp 45 -50 o. C/75 h Heat to dissolve Ca lactate Addition of H 2 SO 4 (removal of Ca SO 4) Filter and concentrate Addtion of Hexacyanoferrant (removes heavy metal) Purification (Ion exchange) Concentration Lactic acid

Antibiotics by Fermentation Technology Antibiotics are produced industrially by a process of fermentation, where the source microorganism is grown in large containers (100, 000 – 150, 000 liters or more) containing a liquid growth medium.

Streptomycin ØSecondary metabolite produced by Streptomyces griseus. ØChange in environment condition and substrate availability influence final product. ØIn fermentation a soyabean based medium is used with glucose as carbon source. ØNitrogen source is combined in soyabean meal, limits growth. ØAfter growth the antibiotic levels in the culture begin to increase. Source: www. indiamart. com

Phases during fermentation of streptomycin PHASE 1: Rapid growth producing mycelial biomasss. Little production of Streptomycin is obtained. Proteolytic activity of the microbe releases NH 3 to the medium from the soybean meal, causing a rise in p. H The glucose and NH 3 released are consumed during this phase. The p. H remains fairly constant-between 7. 6 and 9. 0. PHASE 2: Additional production of mycelium. Streptomycin accumulates in the medium. PHASE 3: Process has completed. Finally the mycelium is separated by filtration and antibiotic recovered.


PRODUCTION OF PENICILLIN • Penicillin was the first important commercial product produced by an aerobic, submerged fermentation • First antibiotic to have been manufacture in bulk. • Used as input material for some semi synthetic antibiotics. • It is fermented in a batch culture

• When penicillin was first made at the end of the second world war using the fungus Penicillium notatum, the process made 1 mg dm-3. • Today, using a different species (P. chrysogenum) and a better extraction procedures the yield is 50 g dm-3. • There is a constant search to improve the yield.

The yield of penicillin can be increased by: • Improvement in composition of the medium • Isolation of better penicillin producing mold sp. Penicillium chrysogenum which grow better in huge deep fermentation tank • Development of submerged culture technique for cultivation of mold in large volume of liquid medium through which sterile air is forced.

Primary and Secondary Metabolites • Primary metabolites are produced during active cell growth, and secondary metabolites are produced near the onset of stationary phase.

Commercial Production Of Penicillin • Like all antibiotics, penicillin is a secondary metabolite, so is only produced in the stationary phase.

INDUSTRIAL PRODUCTION OF ANTIBIOTICPENICILLIN • The industrial production of penicillin was broadly classified in to two processes namely, • Upstream processing • Downstream processing

UPSTREAM PROCESSING • Upstream processing encompasses any technology that leads to the synthesis of a product. Upstream includes the exploration, development and production.

DOWNSTREAM PROCESSING • The extraction and purification of a biotechnological product from fermentation is referred to as downstream processing.

UPSTREAM PROCESSING INOCULUM PREPARATION • The medium is designed to provide the organism with all the nutrients that it requires. • Inoculation method- submerged technique • Spores -major source of inoculum

RAW MATERIALS • • • CARBON SOURCES: Lactose acts as a very satisfactory carbon compound, provided that is used in a concentration of 6%. Others such as glucose & sucrose may be used. NITROGEN SOURCES: Corn steep liquor (CSL) Ammonium sulphate and ammonium acetate can be used as nitrogenous sources. MINERAL SOURCES: Elements namely potassium, phosphorus, magnesium, sulphur, zinc and copper are essential for penicillin production. Some of these are applied by corn steep liquor. • Calcium can be added in the form of chalk to counter the natural acidity of CSL • PAA- precursor

FERMENTATION PROCESS • The medium is inoculated with a suspension of conidia of Penicillium chrysogenum. • The medium is constantly aerated and agitated, and the mould grows throughout as pellets. • After about seven days, growth is complete, the p. H rises to 8. 0 or above, and penicillin production ceases

STAGES IN DOWNSTREAM PROCESSING Removal of cells • The first step in product recovery is the separation of whole cells and other insoluble ingredients from the culture broth by technique such as filtration and centrifugation.

ISOLATION OF BENZYL PENICILLIN • The PH is adjusted to 2 -2. 5 with the help of phosphoric or sulphuric acids. • In aqueous solution at low PH values there is a partition coefficient in favor of certain organic solvents such as butyl acetate. • This step has to be carried out quickly for penicillin is very unstable at low PH values. • Antibiotic is then extracted back into an aqueous buffer at a PH of 7. 5, the partition coefficient now being strongly in favor of the aqueous phase. The resulting aqueous solution is again acidified & re-extracted with an organic solvent. • These shifts between the water and solvent help in the purification of penicillin.

The main stages of Penicillin production are:



Fermented Meat 87

1. Introduction Meat is the flesh (muscle tissue ) of warm-blooded animals, but fermented specialties from poultry ( sausages as well as cured and smoked fermented poultry) are available. What is fermented sausage? A sausage is fermented if -its p. H below 5. 6 and D-lactic acid content above 0. 2% -its colour is heat-stable -its texture is no longer crumble -its aroma is typical -lactic acid bacteria predominate -Enterobacteriaceae counts are low 88

a) Nutritional Role of Meat in the Human Diet: • essential component of the human diet to ensure optimal growth and development. • as a concentrated source of a wide range of nutrients. • high digestibility required relatively smaller guts. • meat and meat products has increased with the affluence of the consumer. • fat content of meat as consumed is around 2 to 5%. • protein of high biological value. • micronutrient such as iron, zinc, vitamin B 1, niacin equivalents, and vitamin B 12 significantly contribute to the nutritional value of meat. • red meat contains 50 -60% of iron in the hame from (from hemoglobin and myoglobin). 89

Table. 2 Classification of fermented sausages 90

2. The history and culture related to fermented meat. • Meat is extremely susceptible to microbial spoilage. • meat as a substrate are optimal for the growth of bacteria. • water activity and p. H are 0. 96 to 0. 97 and 5. 6 to 5. 8, respectively • nutrients and growth factors are abundantly available. • storage and preservation of meat is necessary for the suppression of microbial growth or the elimination of microorganisms and prevention of recontamination. 91

2. The history and culture related to fermented meat • The traditional methods which comprise reduction - 1) water activity ( drying, salting) and/ or p. H (fermentation, acidification) 2) smoking, storage at refrigeration or freezing temperatures, 3) use of curing aids (nitrite and nitrate) • meat may also contain bacterial food pathogens. • meat has to be of high quality with regard to hygiene and microbial counts. 92

3. The fermentation process Fermentation process : two types -foods from a comminuted matrix -whole meat products. 93

A. Fermentation of a Comminuted meat matrix a) Variables in sausage production Variables include: • The particle size of the comminuted meat and fatty tissue (1 and 30 mm) • The selection of additives (curing salt, nitrate, ascorbic acid, sodium glutamate and glucono-∂lactone -source glucose. • The temperature /humidity (below 2 to 3℃, the temperature is raised usually to > 20℃ and > 28℃, but maximum higher temperatures (32 to 38℃). 94

• • The diameter of the sausages The nature of the casings smoking Heating after fermentation Supporting the development of mold growth on the surface or establishing a special tight surface film (e. g. coating with a titanium dioxide film) • Dipping in antifungal preparations ( sorbic acid or pimaricin) • p. H-4. 8 to 5. 4 95

Table. 3 96

Species Employed in Meat Starter Cultures • Bacteria: Lactic Acid Bacteria such as Lactobacillus acidophilus, Lb. alimentarius, Lb. curvatus, Lb. plantarum etc, Lactococcus lactis, Pediococcus acidilactici, P. pentosaceus • Actinobacteria : Kocuria Bifidobacterium spp. varians, Streptomyces griseus, • Staphylococci: Staphylococcus xylosus, S. carnosus ssp. • Halomonadaceae : Halomonas elongata • Fungi: Penicillium nalgiovense, P. chrysogenum, P. camemberti • Yeasts: Debaryomyces hansenii, Candida famata 97

B. Fermentation of Whole Meat Products (HAM) • curing by salting (with or without the use of nitrite and/or nitrate) • to achieve a water activity of ∠ 0. 96 (equivalent to 4. 5% sodium chloride) • temperatures (50 C)―the salt will diffuse to the deepest part of meat • overcoming the food poisoning through Clostridium botulinum contamination. • after equilibrating the salt concentration and flavor development, the temperature is raised to 15 to 250 C to ripen the ham. • optimum flavor has no changed at least 6 to 9 months, maximum 18 th month. • at the end of ripening step, the moisture has been reduced by 25% and salt 4. 5 to 6%) 98

4. Composition and changes during fermentation • growth of LAB and concomitant acidification of the product. • reduction of nitrates to nitrites and formation of nitrosomyoglobin • solubilization and gelification of miofibrillar and sarcoplasmic proteins • degradation of proteins and lipids • dehydration 99

a) Fermentation Microflora • sausage minces favor the growth of Micrococcacea and Lactobacilli (5× 108 to 109 CFU/g) • Micrococcacea such as Kocuria varians, Staphylococcus carnosus or S. xylosus grow to cell counts 106 to 107 CFU/g, when nitrate cure is applied. • inhibited the growth of organism • the predominant microorganism is isolated • growth of Staphylococcus occurs • Penicillium constituted 96% of the microflora • the nontoxigenic species Penicillium nalgiovense was most frequently isolated • the halotolerant yeast (Debaryomyces hansenii) is the predominant 100

b) Acidification, Dehydration, and Microbial Antagonism • isoelectric point of meat proteins (p. H 5. 3 to 5. 4) • increase the ionic strength • sodium chloride and lactate in fermented sausages develop taste of the product. • acidification and drying are importance for inhibition of the growth of pathogens. • low p. H and water activity exert an inhibitory effect towards pathogens. • lactic and acetic acids are the major fermentation products • the dry matter content 50 -75% • the water activity values. 86 -. 92 depend on ripening 101

c) Proteolytic and Lipolytic Degradation during fermentation • Peptides and amino acids accumulate to levels of about 1% dry matter • Peptides and amino acids act as flavor enhancers and synergists. • excess proteolysis may result in bitter and metabolic off-flavor • amino acids and peptides are utilized by microorganisms for the conversion to flavor volatiles • the bioactive peptides is influenced by lactic fermentation • Kocuria varians is inhibited by environmental conditions • Lb. casei utilizes peptides released from pork muscles • fat content 40 -60% of dry matter • long chain fatty acids are released from triglycerides and phospholipids • free fatty acids are found 5% of the total fatty acids. • polyunsaturated fatty acids is higher than saturated fatty acids. 102

d) Generation of Flavor volatiles Routes: • by lipolysis and hydrolysis of phospholipids, followed by oxidation of free fatty acids. • microorganisms produce organic acids: convert amino acids and peptides to flavor-active alcohols, aldehydes, and acids • modify products of lipid oxidation • aroma is determined by the addition of spices, smoking, or surface-ripening with yeasts or molds. 103

e) Biogenic amines • histamine, tyramine, phenylethylamine, tryptamine, putrescine and cadaverine not exceeding 100 mg/kg. • are mainly derived from bacterial decarboxylation of amino acids • putrescine and cadaverine are produced by the Gramnegative spoilage flora • starter cultures inhibit rapidly metabolism of Gram negative bacteria • effectively reduce tyramine levels in fermented sausages 104

Product Diversity and Sensory Properties • The main desirable effects of starter micro-organisms on flavor and taste of fermented meats are • formation of lactic acid • transformation of compounds from abiotic breakdown of lipids • degradation of peptides and amino acids formed by meat proteases • Indirect effects are • consumption of oxygen • reduction of nitrate • protein degradation by mould proteases 105

Sucuk • One of the most important and widely consumed traditional Turkish meat product, • Dried, uncooked, cured and fermented sausage, • Produced from beef or buffalo meat Consist of ground meat and sheep tail fat and curing agents (nitrite and nitrate), with various spices including cumin, garlic, salt, and black and red pepper 106

Sucuk processing stages Stuffing sausage mixture into natural sausage casings Fermentation at 22 -23ºC by either microorganisms naturally present or added starter cultures Drying for several weeks at ambient temperature and humidity due to fermentation, the final product has an increased shelf life as a consequence of the inhibition of the pathogenic and spoilage bacteria, 107
- Slides: 107